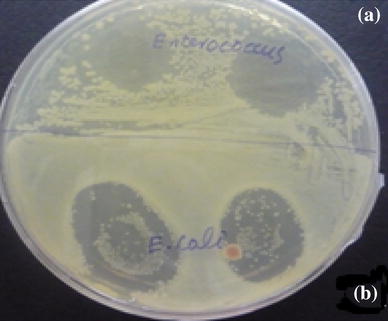
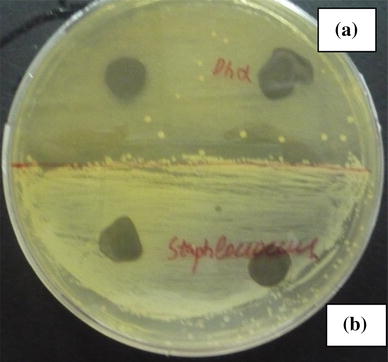

Results and discussion
The morphology of the materials was characterized by TEM, which demonstrated and confirmed the formation of NWs at 160 °C having diameter within 60–70 nm and length in few microns. At 160 °C the exclusive product is NWs as shown in Fig.
1
a. It has been observed that there are distinct spots showing
f
NPs of Ag over the surface of NWs. The diameter of these particles is in about 8–10 nm. It was revealed that experimental procedure of gradual decrease in temperature proved helpful to produce nano-assembly, comprising two different dimensions, i.e., 1D and 3D, where 1D is NWs and 3D is
f
NPs. This is designated as 3D–1D nano-assembly. The
f
NP has more potential to interact with probe organic molecule or biomolecules as compared to NWs [
14
] and NWs are suitable to transduce signals. Therefore, nano-assembly was desirable where
f
NP can serve as anchoring site for probe molecule/agents and NWs could serve the purpose of transducing the signal that may result from the probe and target interaction. In this way, the as-synthesized nano-assembly can act as biosensor to find the target molecules by the interaction of probe and transduce their detectable signals through NWs. It is also expected that at nano-scale level there would be more anchored probe molecules and thus these would increasingly interact with target molecules which would result the strong or easily detectable signal. Therefore, the designed nano-assembly would possess the bio-analytical application.
TEM pictures:
a
3D–1D nano-assembly (
f
NPs adsorbed onto Ag NWs),
b
growing shell-3/1D,
c
fully developed shell-3/1D nano-assembly,
d
3D–3D nano-assembly (Ag
f
NPs adsorbed over
b
NPs)Fig. 1

Similarly, the observation under TEM expressed in Fig. 1 b and c with reference to experiment carried out at 140 °C, which revealed the formation of NPs as well as NWs, where each structure is enclosed by nanoshell of same materials having diameter about 8 nm. It was also demonstrated that 140 °C is critical temperature for the formation of NWs, as temperature below to this is favorable for the production of NPs and above it is suitable to produce NWs [ 15 ]. Therefore, this temperature was found suitable for the production of NPs as well as NWs. In this case, temperature was again gradually decreased which produced f NPs. Moreover, subsequent rise in temperature from room temperature to its original setting proved helpful to merge these f NPs over surface of b NPs and NWs, and thus created shell-like morphology. This kind of nano-assembly is labeled as shell-3/1D. The shell-3/1D nano-assembly has two types of appearances, i.e., coalescence of f NPs in form of shell and making of perfect nanoshell around NPs and NWs. Therefore, both are expressed separately in Fig. 1 , b and c, respectively, for clear differentiation. The as-synthesized nanoshell over the same materials is helpful to protect the enclosed nanostructure and it is also expected to express its enhanced catalytic and bioactivity due to significantly reduced size.
The TEM pictures of experiment that was performed at 120 °C are displayed in Fig. 1 d, which demonstrated spherical morphology of NPs having diameter 40–45 nm. These NPs are also being adsorbed with f NPs having diameter again about 8 nm. The adsorption of f NPs in each case restricted their agglomeration that is a usual trend of such a small particles. Therefore, the technique proved helpful to limit their coalescence and exposed their surface which is prerequisite for catalytic, antimicrobial and optical behavior. This technique may also be used to immobilize quantum dots over such substrate.
The strategy to fabricate conjunction of f NPs over NWs and b NPs or making the shell of very small diameter over these nanostructures was achieved in single step that is quite advantageous. Since in the separate synthesis of f NPs and bigger nanostructures, and then their merging is a laborious process, which does not assure the production of such unifications. However, in this technique, the synthesis of nano-assembly, its washing and separation from reaction mixture is quite easy due to presence of bigger nanostructures which can easily settle down by centrifugation. Moreover, in separate synthesis some linkers are required for combining different nanostructures to develop the nano-assembly, and in our methodology no such linker is required [ 16 ].
The energy dispersive X-rays spectroscopy (EDS) is displayed in Fig.
2
and respective Table
2
. It has confirmed that both components in each kind of assembly are constituted by same material that is Ag which is 97 %. The presence of 3 % C is due to the membrane of C over a copper grid (Table
2
).
EDS and its table showing the dominant constituent of Ag in whole assembly EDX of Ag nano-assembly Elem Weight (%) Atomic (%) C K 03.00 21.80 AgK 97.00 78.20Fig. 2

Table 2
The SPR of
f
NPs adsorbed over Ag NWs (3D–1D), NWs having shell (shell-3/1D) and
f
NPs over
b
NPs (3D–3D) was analyzed by UV–Vis spectrophotometer. The SPR behavior is displayed in Fig.
3
. It has been revealed as the nano-assemblies changed from 3D–1D, shell-3/1D and 3D–3D, their SPR absorbance intensively increased along with blue shift. Moreover, it has been seen that longitudinal and trans-sectional SPR of NWs in 3D–1D nano-assembly is not differentiated due to even growth of
f
NPs around its surface. In case of shell-3/1D nano-assembly, the product obtained at 140 °C showed gradually enhanced SPR and relatively blue shifted. Similarly, the SPR intensity of 3D–3D nano-assembly is again more intense and blue shifted. If the SPR data are compared with smooth respective nanostructures [
17
] and it was found the SPR is quite more in case of merged nanostructures, because in merged form
f
NPs has more contribution in SPR character.
UV–Vis spectrum showing SPR of Ag nano-assemblies assigned as 3D–1D, shell-3/1D and 3D–3D, respectivelyFig. 3

Furthermore, the Ag and its nanostructures have well recognized antimicrobial activities [ 18 , 19 ], but still no study has been carried out that Ag nanostructures synthesized by polyol reduction method does possess such peculiarities. Likewise, the smaller or finer Ag nanostructures are believed to demonstrate more antimicrobial behavior; therefore, we analyzed the antimicrobial behavior of shell-3/1D and 3D–3D nano-assemblies which are smaller and finer nano-assemblies as compared to 3D–1D nano-assembly. Thus, the antimicrobial activities of Ag nano-assemblies, synthesized by polyol reduction method were assayed against gram positive bacteria like Enterococcus faecalis and staphylococcus aureus, and gram negative like E. coli 0157 : H7 and DH5α by employing UV–vis spectrophotometer and Kirby-Bauer process whose strains number are given in “ Materials ”.
In this experiment, LB broth nutrient media were used, where at first UV–vis absorption of shell-3/1D and 3D–3D Ag nano-assemblies were measured and then UV–vis absorption of just bacterial samples was taken for comparative account. In continuation of experiment, the shell-3/1D and 3D–3D Ag nano-assemblies were mixed separately with bacterial samples of gram positive bacteria like
Enterococcus feacalis
and
Staphylococcus aureus,
and gram negative bacteria like
E. coli 0157
:
H7
and
DH5α
for 8 h and then their UV–Vis absorption was noted, which is displayed in Figs.
4
and
5
, respectively. The antimicrobial activities of shell-3/1D and 3D–3D Ag nano-assemblies in accordance with above pattern are given in Figs.
4
and
5
, respectively. According to the data shown in Figs.
4
and
5
, bacteria after 8 h show significant growth, which was demonstrated by linear increase in UV–vis absorption, while pure nano-assemblies designated as shell-3/1D and 3D–3D of Ag showed SPR absorption in region of 410–430 nm, respectively. Both bacterial and nano-Ag absorption seemed to appear in same region that is 410–430. The coincidence of both absorptions in same region is quite useful for analysis purpose, as in case of inactivity both absorptions would add up and in case of activity they would suppress the bacterial absorption along with some change. Similarly, when Ag nano-assemblies were mixed with bacterial samples, the bacterial absorption decreased and nano Ag-SPR absorption red shifted. The decrease of UV–Vis absorption for bacterial sample clearly demonstrated the antimicrobial effects of Ag nanostructures. The red shift might be due to agglomeration of nanostructures over the surface of bacteria [
20
]. Hence, UV–vis absorption technique confirmed the antimicrobial activity of Ag nanostructures, which were prepared by the polyol reduction method against gram positive and negative bacteria.
Shell-3/1D nano-assembly and its antimicrobial behavior against
c
Enterococcus faecalis
,
d E. coli 0157
:
H7, e DH5α
,
f Staphylococcus aureus
, respectively 3D–3D nano-assembly and its antimicrobial activity against
c
Enterococcus faecalis
,
d E. coli 0157
:
H7
,
e DH5α
,
f staphylococcus aureus
, respectivelyFig. 4

Fig. 5

To further validate the antimicrobial attributes of Ag synthesized by polyol reduction method, the Kirby-Bauer process was used where nutrient media was LB agar [
21
]. The results are shown in Figs.
6
and
7
, respectively. Each plate is divided into two halves and two kinds of bacteria (inoculum) were grown in each plate and only one kind is grown in each half of the plate. In Fig.
6
, the upper part of the plate contains
Enterococcus feacalis
and the lower part of plate has
E. coli 0157
:
H7
which are gram positive and negative bacteria, respectively. The left part of the plate was tested for shell-3/1D and right part was analyzed for 3D–3D nano-assemblies. Over each part, at the left side the drop of shell-3/1D was dropped and at right side, the drop of 3D–3D nano-assemblies was dropped. In this experiment, 50 μL of each nano-Ag was dropped over the growing lawn of
Enterococcus faecalis
and
E. coli 0157
:
H7
bacteria over LB agar media. The diameter of drop was approximately 0.7 cm. After incubation period of bacterial culture with Ag nano-assemblies, the clear zone of inhibition was observed which is about 2–2.5 cm measuring diameter for
E. coli 0157
:
H7
and
Enterococcus faecalis,
respectively.
The shell-3/1D nano-assembly (
left
) and 3D–3D nano-assembly (
right
) showing antimicrobial activities for
a
Enterococcus faecalis
,
b
E. coli 0157
:
H7 The shell-3/1D nano-assembly (
left
) and 3D–3D nano-assembly (
right
) showing antimicrobial activities for
a
DHα
,
b
Staphylococcus aureus
, respectivelyFig. 6
Fig. 7
Similarly, in Fig.
7
, the upper part of the plate contains
DH5α
and lower part of same plate possessed
Staphylococcus aureus
. Herein, similarly nano-Ag was dropped as according to Fig.
6
. In this experiment, 10 µL of each nano-Ag was dropped whose diameter was about 0.25 cm. After incubation period of bacterial culture with Ag nano-assemblies, the clear zone of inhibition of measuring diameter about 1.2–1.5 cm was observed for
DH5α
and
Staphylococcus aureus
. The concentration of both solutions was same, which is 100 µg/mL. Moreover, the left part of each plate in Figs.
6
and
7
reflected the effect of shell-3/1D and right part of each plate is observed for 3D–3D nano-assembly. It is clearly reflected from the each plate that colonies of each microbe of gram positive and gram negative bacteria could not grow in the region where aqueous drops of nano-Ag structures were employed. Moreover, at each site of Ag drops over both plates there was clear zone of inhibition, which demonstrated and validated that Ag nano-assemblies produced from polyol reduction method possess typical antimicrobial activities, as it was reflected against gram positive bacteria like
Enterococcus
and
staphylococcus aureus,
and gram negative bacteria like
E. coli 0157
:
H7
and DH5α. Furthermore, polyol reduction is a versatile method that has potential to produce the controlled morphology of metal nanostructures, but herein it was proved absolutely unique as it has also potential to produce nano-assemblies. It is also assumed that ionization of nano-Ag produced by polyol method is slow since zone of inhibition is not very enlarged. This trend is believed to be environmentally friendly as cautioned by Smitha Pillai [
22
], where excess release of Ag
+
was reported from physically synthesized Ag nanostructures and that have great toxic effects over fisheries (Table
3
).
Showing antimicrobial activities of Ag nano-assemblies in LB agar nutrient media S/no. Bacterial strain Concentration of nano-Ag (µg/ml) Volume of drop (µL) Zone of inhibition (diameter) 1 50 50 2–2.5 cm 2 50 50 2–2.5 cm 3 DH5α (Invitrogen™) 50 10 1.2–1.5 4 50 10 1.2–1.5Table 3